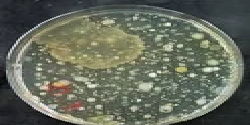

True Analyticas Company
True Analyticas Company
True Analytica is one of India’s largest and most comprehensive contract analytical testing services companies with facilities and personnel spread across the globe. We provide multi-disciplinary contract research and testing services with international quality systems and state-of-the-art infrastructure, combined with highly specialized skill sets, such as industry and technical expertise and an understanding of the global and local regulatory environments. The analysts in the laboratory are highly qualified and trained practically in various analytical procedures. We are constantly scanning the horizon for opportunities and offering our customers the best to accelerate and improve their capabilities.
Preview
No. 21, New Street Kottur,,
Chennai - 600085
Chennai - 600085
Contact Details

Total Plate Count Biological Testing
Features:
Good quality
Durable
Reliable Backed by rich industry experience, we are engaged in offering Micro Biological Analysis Services. This analysis of foods is conducted in segregated laboratory environment to avoid cross contamination. Our skilled professionals and lab experts make use of ultra modern testing procedures and tools to test the presence of Shigella in humans and apes that is a genus of Gram-negative, nonmotile, nonspore forming, rod-shaped bacteria. Quality assured results and reliability are the foremost factors that help us to beat the competition.
Chennai - Tamil Nadu